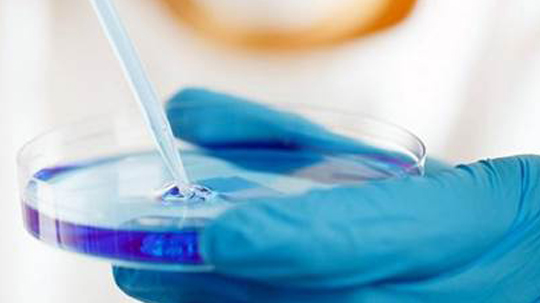

05 Sep La cura del ELA saldrá de Israel
La mayoría ya nos hemos cansado un poco de una «payasada» que da vueltas en las redes sociales llamada «desafío del balde de agua fría».
Parece poco probable que de esa campaña salga algo realmente prometedor para los enfermos de este mal. Sin embargo en Israel el panorama es más alentador y hoy les contamos porque.
El Ice Bucket Challenge o también llamado desafío del balde de agua fría, es una campaña publicitaria solidaria que busca generar un «tipo de conciencia» poniéndose en el lugar de las personas que padecen una enfermedad muy extraña llamada Esclerosis Lateral Amiotrófica (ELA, o ALS por sus siglas en inglés), enfermedad degenerativa progresiva que ataca las neuronas motoras, haciendo que el cuerpo se sienta como si le tiraran una cubeta de agua fría, ya que el organismo baja mucho su temperatura.
Hablabamos de «payasada» cuando nos topamos con un video publicado por la compañía surcoreana Samsung, el modelo Galaxy S5, se somete al desafío Ice Bucket Challenge y además convocó a sus smartphones competidores (el iPhone 5S de Apple y el Nokia Lumia 930) a que puedan hacer lo mismo.
Entre las personalidades relevantes que padecen esta enfermedad se encuentra por ejemplo el físico Stephen Hawking.
Es curioso a la luz de esta nota que haya sido el propio Hawking quien se haya sumado hace algún tiempo a los boicots en contra de Israel.
Más interesante seria conocer los comentarios del propio Hawking al leer esta nota.
El desafío de la cubeta, también llamado así, consiste en arrojarse una cubeta de agua fría, que da la opción de desafiar a otras tres personas para que lo cumplan en las próximas 24 horas o deberán donar 100 dólares.
El dinero se recauda a beneficio como donación para la Asociación de Esclerosis Lateral Amiotrófica que estudia la enfermedad.
La ALS Association es una organización sin fines de lucro que tiene como principal fin la protección y cuidado y sobretodo asistencia a las personas que padecen esta enfermedad, a través de una interconectada red que tiene como sede principal Estados Unidos, además de un programa de investigación que está por todo el mundo con la labor de descubrir tratamientos y una posible cura para la enfermedad.
Personalidades que se han sumado al desafío para apoyar la causa cuentan a Alicia Machado, George W. Bush, Lionel Messi, Bill Gates, Taylor Swift, Neymar, Javier Hernandez Balcazar, Cristiano Ronaldo, Miguel Herrera, Migbelis Castellanos, Patricia Zavala, Lady Gaga, Shakira,Juanes, Demi Lovato, y Ashley Benson son algunos de los que han «aceptado el reto».
;
Pero mientras todos estos «famosos» se divierten, un grupo de científicos israelíes (de quienes hemos contado hace ya algún tiempo) ha conseguido frenar por primera vez, el proceso degenerativo que produce la esclerosis lateral amiotrófica (ELA) con una nueva técnica de reinyección de células madre del propio paciente.
Ahora una nota en el conficencial.com da cuenta que la investigación, realizada en los últimos años en el hospital universitario Hadasa Ein Karem de Jerusalem, ha conseguido frenar por completo el avance de la enfermedad en algunos pacientes y en otros ha logrado incluso que se produzca una ligera mejoría en los músculos degenerados.
«El problema con la ELA y enfermedades similares es que un grupo de células nerviosas se degenera hasta morir de forma irremediable», explicó el profesor Eldad Melamed, científico de la Universidad de Tel Aviv que participa en el proyecto, alentado por la empresa privada israelí Brainstorm.
La esclerosis lateral amiotrófica, se origina cuando las motoneuronas dejan de funcionar y van causando una parálisis muscular que acaba en la muerte a los pocos años.
Melamed explicó que la investigación ha sido muy difícil debido a que se desconocen las causas por las que estas neuronas dejan de funcionar y comienzan el proceso degenerativo, por lo que decidieron trabajar sobre las células madre del propio paciente.
«Las extraemos de la médula ósea, las limpiamos y las reproducimos en grandes cantidades. Después las tratamos con un proceso químico que las convierten en neuronas y las inyectamos en la espina dorsal y en los músculos afectados», explicó sobre la técnica que ha desarrollado su empresa.
Los resultados que aseguran haber conseguido oscilan entre haber frenado la enfermedad en algunos pacientes y haberla detenido por completo en otros.
El informe afirma que la nueva técnica abre una ventana al optimismo para miles de pacientes, pero que está aún en fases preliminares de investigación y debe completar ensayos clínicos en Israel y en Estados Unidos.
Fuente: Latam Israel


